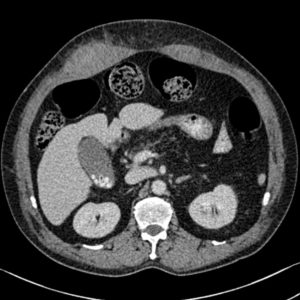
Tụ máu cơ thành bụng

XƯƠNG KHỚP
Hiển thị 381–400 của 544 kết quảĐã sắp xếp theo mới nhất
-

Dị dạng xương khớp
Lượt xem: 172» 21-04-2019 -

Hố Pitt
Lượt xem: 181» 19-04-2019 -

Vỡ xương hộp sọ
Lượt xem: 276» 17-04-2019 -

Vỡ xương hộp sọ
Lượt xem: 183» 17-04-2019 -

Gãy giật
Lượt xem: 278» 19-03-2019 -

Vỡ xương đá
Lượt xem: 1672» 14-03-2019 -

Chordoma
Lượt xem: 273» 02-03-2019 -

U máu xương
Lượt xem: 403» 25-02-2019 -

Tụ máu cơ thành bụng
Lượt xem: 213» 25-02-2019 -

Rách dây chằng bên
Lượt xem: 167» 09-02-2019 -

Xương đặc đốm
Lượt xem: 201» 08-02-2019 -

Gãy mắt cá trong
Lượt xem: 428» 06-02-2019 -

U mỡ màng xương
Lượt xem: 213» 05-02-2019 -

Vỡ xương ổ mắt
Lượt xem: 306» 02-02-2019 -

Viêm cột sống dính khớp
Lượt xem: 288» 31-01-2019 -

U sụn
Lượt xem: 0» 28-01-2019 -

Chấn thương khớp vai
Lượt xem: 418» 27-01-2019 -

Vỡ xương hộp sọ
Lượt xem: 154» 26-01-2019 -

Dị vật phần mềm
Lượt xem: 163» 26-01-2019 -

Loạn sản xơ xương
Lượt xem: 793» 26-01-2019